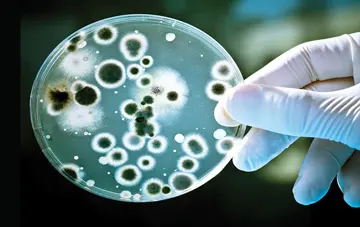

شماره ۱۱۷۰
روزانه ۱۷میلیونفرد آلوده بهHIV درسراسر جهان داروهایی مصرفمیکنند بهامیداینکه ویروس درون بدنشان را بدون راه فرارگذارند. اینگروه تا آخرعمر و پیوسته هرروز این داروها را باید مصرفکنند و بدونتوجه بهمیزان داروهایمصرفی،آنها همیشه ناقل ویروسی هستند که درون سلولهایخونی سفیدشان مخفی باقیمیماند و اگر آنها مصرف داروها را متوقفکنند، HIV ازحالت پنهان خارجگشته و سیستم ایمنی بدنشان را بهطورکامل منهدممیکند و بهاینترتیب منجربه بیماری شناخته شدهای باعنوان ایدز میشود و پیشازآنکه منجربه مرگ آنها گردد، بهطور بالقوه به دیگران منتقلمیشود.